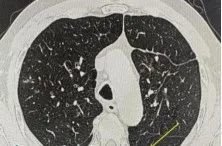
男子咳嗽数月以为小毛病,一查竟惹上“致命杀手” 男子咳嗽数月以为小毛病,一查竟惹上“致命杀手”

最近,福建65岁的张大爷
遇到了一件烦心事
他持续咳嗽,长达4个多月
却找不到原因!
万万没想到,到医院一查
竟是被这种“致命杀手”盯上
原因更让人意外……
张大爷因持续咳嗽、咽痛、声音嘶哑,而辗转多家医院治疗,却始终找不到病因。家人都很着急,以为是普通的咽喉炎或肺炎,但各种常规治疗都没有效果。
近日,张大爷到福建一医院的呼吸内科就诊,入院后通过专业检查,才揭开了这个谜团——原来是一种叫“马尔尼菲篮状菌”的真菌在作怪。

更让人意外的是,张大爷并不是我们通常认为容易感染这种病菌的免疫力低下患者,他的身体状况相对良好,免疫功能正常,却感染了这种素有“致命杀手”之称的真菌。
经过接诊医生详细的询问,发现张大爷有竹鼠接触史。原来,张大爷居住在山区,每到笋季总要到竹林间挖笋,碰到竹鼠出没也是常有的事。
那么
有接触竹鼠史和
感染马尔尼菲篮状菌之间
有什么关系呢?
一起往下看看
什么是马尔尼菲篮状菌病?
医生介绍,马尔尼菲篮状菌是一种生活在自然环境中的真菌,主要分布在东南亚地区和我国南方,竹鼠是它们的天然宿主。当人们吸入含有这种真菌孢子的空气时,就可能发生感染。
这种真菌感染的症状往往很隐蔽,患者多表现为咳嗽、咳痰、胸痛,很容易被当作普通的肺炎或咽喉炎来处理。肺部影像学也缺乏特征性改变,多类似于肺炎、肺结核或肺脓肿病变。正是因为这些症状、检查缺乏特异性,很多患者像张大爷一样,在确诊前经历了漫长的求医过程。
过去,医学界认为这种病主要感染免疫力严重低下的人群,特别是HIV感染患者。此外,老年人、有慢性疾病的患者、长期服用激素等药物的人群也是高风险人群。但张大爷的病例提醒我们,即使是免疫功能正常的人,如果有特定的环境接触史,同样可能“中招”。
如果您在竹林附近居住或工作,可能接触过竹鼠等野生动物,或在流行地区居住或旅行,那么您就属于这种疾病的高危人群。
如何预防和应对?
预防马尔尼菲篮状菌感染,最重要的是减少高危环境的暴露。如果必须到竹林等环境中活动,建议佩戴防护口罩,避免直接接触野生动物,注意个人卫生,勤洗手。平时要保持良好的生活习惯,均衡饮食,适量运动,增强自身免疫力。
当出现持续2周以上不愈的咳嗽、咳痰、咽痛,特别是伴有发热、胸痛、气促等症状时,应该立即到正规医院就诊。就医时,一定要详细告诉医生您的症状、发病时间,以及是否有竹林接触史、动物接触史等重要信息。这些看似不起眼的细节,往往是医生诊断的重要线索。
诊断有一定难度
可完全治愈
马尔尼菲篮状菌病诊断具有一定难度,但值得庆幸的是,马尔尼菲篮状菌病是完全可以治愈的!医生表示,目前临床上有多种有效的抗真菌药物,如两性霉素B、伊曲康唑、伏立康唑等。
治疗的关键在于“三早”:早发现、早诊断、早治疗。一旦确诊,患者需要在医生指导下规范用药,不能随意停药或减量。大多数患者经过正规治疗后都能获得良好的效果。
转自福建卫生报


点击右上角![]() 微信好友
微信好友
 朋友圈
朋友圈

点击浏览器下方“ ”分享微信好友Safari浏览器请点击“
”分享微信好友Safari浏览器请点击“ ”按钮
”按钮

点击右上角 QQ
QQ

点击浏览器下方“ ”分享QQ好友Safari浏览器请点击“
”分享QQ好友Safari浏览器请点击“ ”按钮
”按钮
